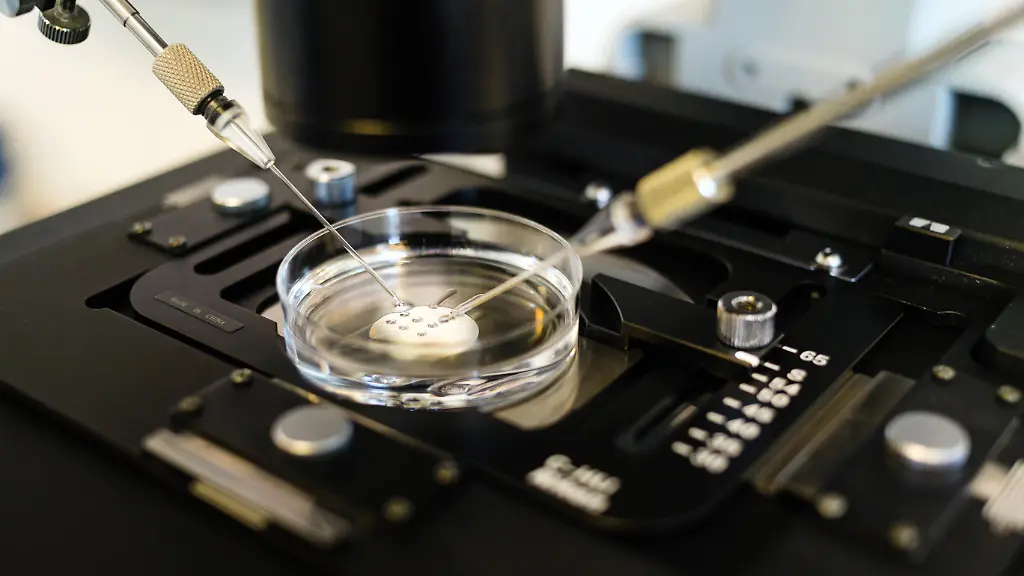
420419974

"Außergewöhnliche Leistung"Frau bringt mit 70 Jahren Zwillinge zur Welt
In einem Krankenhaus in Uganda werden Zwillinge geboren. Das Besondere daran: die Mutter ist bereits 70 Jahre alt. Der Vater der Babys scheint allerdings alles andere als begeistert zu sein.
In Uganda hat eine 70-jährige Frau per Kaiserschnitt Zwillinge zur Welt gebracht. Safina Namukwaya sei damit die älteste Mutter Afrikas, sagte der Arzt Edward Tamale Sali, der Namukwaya während der Schwangerschaft und Geburt betreut hatte. Die Babys - ein Junge und ein Mädchen - wurden demnach in einer Klinik in der Hauptstadt Kampala geboren, in der sich Namukwaya einer In-vitro-Fertilisation unterzogen hatte. Mutter und Kinder seien wohlauf.
"Ich weiß gerade nicht, wie ich meine Freude ausdrücken soll", sagte Namukwaya, die in der ländlichen Region Masaka etwa 120 Kilometer westlich von Kampala lebt. In ihrem Alter sei ihr nicht mehr zugetraut worden, "schwanger zu werden und ein Kind zur Welt zu bringen oder mich um ein Baby zu kümmern", sagte sie. Die Zwillinge seien für sie daher ein "Wunder". Ihr Arzt sprach von einer "außergewöhnlichen Leistung".
Der ugandischen Zeitung "Daily Monitor" erzählte Namukwaya, dass ihre Schwangerschaft schwierig gewesen sei, da ihr Partner sie verlassen habe, als ihm klar wurde, dass sie Zwillinge bekommen würde. "Männern gefällt es nicht, wenn man ihnen sagt, dass man mehr als ein Kind bekommt. Seit ich hier eingeliefert wurde, ist mein Mann nicht mehr aufgetaucht."
Laut dem Sender BBC ist unklar, ob Namukwaya eine gespendete Eizelle eingesetzt wurde, oder eine eigene, die eingefroren wurde, als sie jünger war. Die 70-Jährige sagte, sie habe bereits im Jahr 2020 ein Mädchen zur Welt gebracht - nachdem sie zuvor keine Kinder bekommen konnte und als "verfluchte Frau" verunglimpft wurde.
Die In-vitro-Fertilisation ist eine Methode zur künstlichen Befruchtung. Dabei wird eine zuvor entnommene Eizelle außerhalb des Körpers mit Sperma des Vaters in Kontakt gebracht. Nach einigen Tagen wird der entstandene Embryo - manchmal auch mehrere - in die Gebärmutter der Mutter übertragen. Geht alles gut, wächst ein Baby heran.